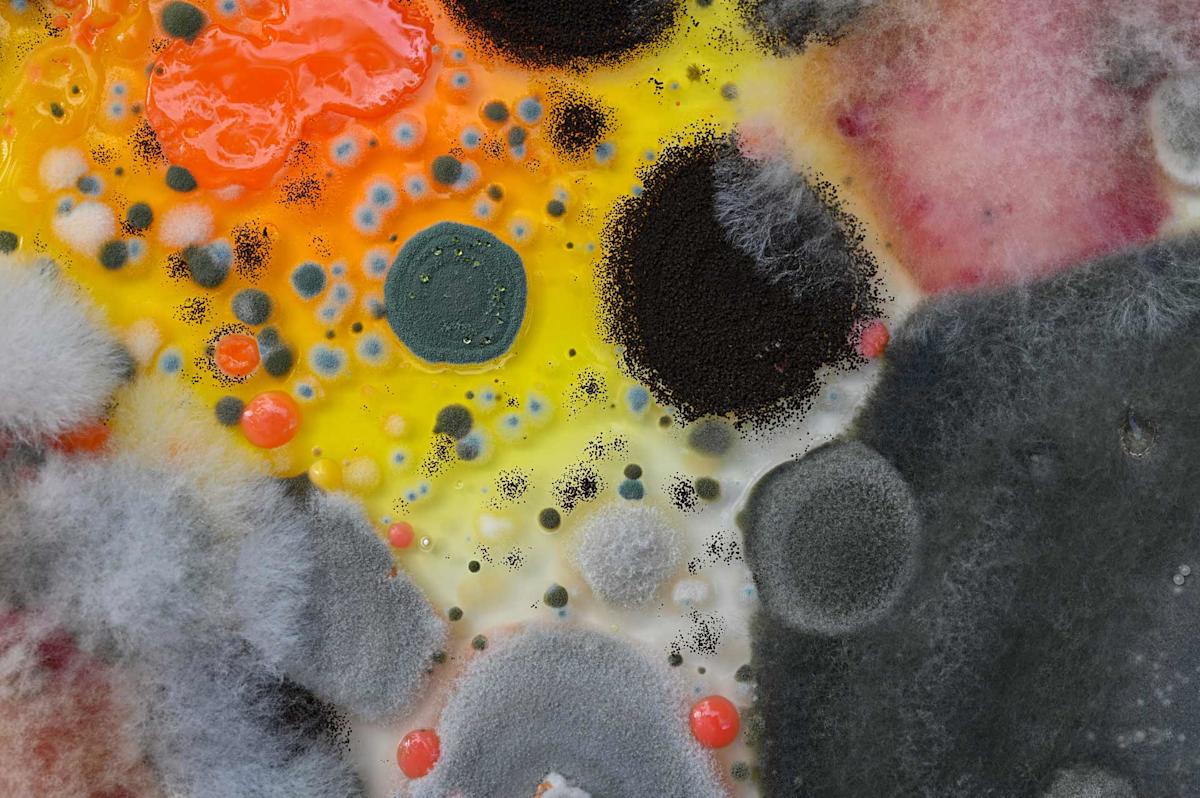
Close-up of colorful mold colonies on a surface, with textures ranging from bright orange and yellow to dark green and black. Various shapes and sizes are present, creating a vibrant and chaotic pattern.

Contamination Series by Selin Balci. Courtesy, Staten Island Museum
Museen & GalerienRandall Manor
Aufschlüsselung: Das Versprechen des Verfalls
This event has already occurred
Beschreibung
Diese Ausstellung soll Aspekte des Zerfalls im Ökosystem hervorheben, die häufig übersehen werden. Mit Arbeiten von sechs zeitgenössischen Künstlern erforscht die Show die Rolle von Plastikverschmutzung und Mikroplastik und wie die Öffentlichkeit dem vertrauen kann, was sie sehen können, um die Welt zu schützen, die wir täglich sehen.
Mehr anzeigen
Ort
Staten Island Museum at Snug HarborSnug Harbor Cultural Center & Botanical Garden 1000 Richmond Terr., Staten Island, NY, 10301
Kontakt
Features
Typ
Kunstgalerien
Wissenschaft und Technologie
Kultur und Geschichte
Museen
Saisonal
Frühling
Sommer
Barrierefreiheit
Für Rollstuhlfahrer geeignet